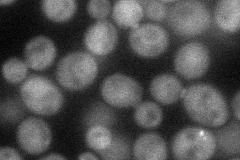
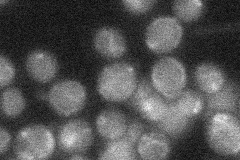

View description
Putative ubiquitin-specific protease, closest paralog of Doa4p but has no functional overlap; concentrates at the bud neck
Localization:
Intensity:
Fold change:
Significance:
-
C’ GFP library in SD

cytosol20.05 -
N' NOP1pr-GFP in SD
cytosol,bud neck43.5501 -
N' TEF2pr-mCherry in SD

bud neck51.6072 -
N' NATIVEpr-GFP in SD
below threshold21.7112 -
N' TEF2pr-VC and Cyto-VN in SD

cytosol32.1892 -
C’ GFP library in SD+DTT

cytosol23.161.15No -
C’ GFP library in SD+H2O2

cytosol18.930.94No -
C’ GFP library in Starvation Media

cytosol19.220.95No -
C’ GFP library on the background of Pup2-DaMP

cytosol -
C’ GFP library on the background of CCT mutant

cytosol20.16311.00507No
